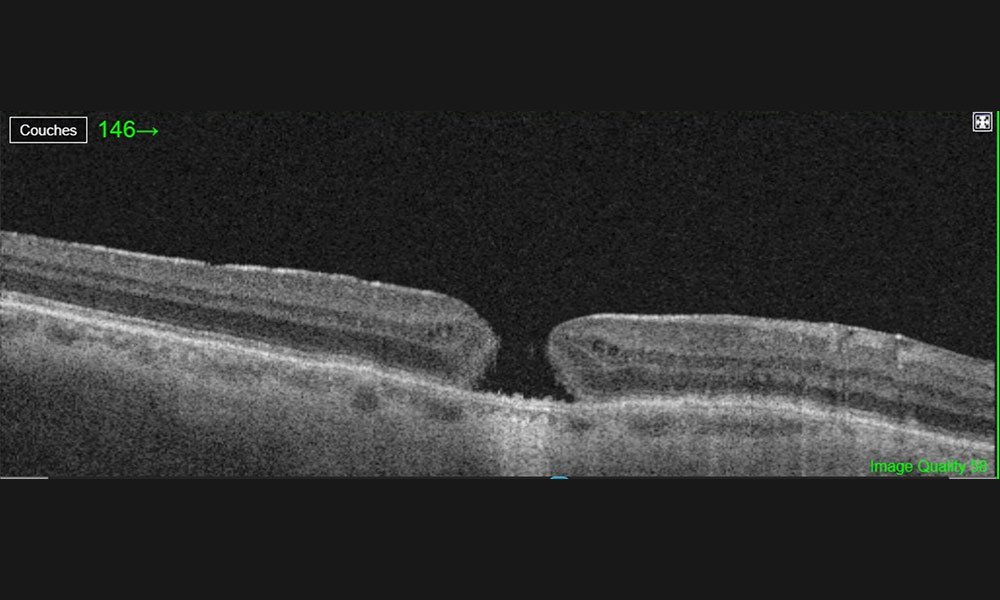
Trou maculaire-Visiop&ocirc;le du beaujolais

Le trou maculaire se réfère à une perte d’une partie du tissu rétinien au niveau de la macula (centre de la rétine). Cela entraîne une baisse voire une perte de la vision centrale. Avec le temps, le diamètre du trou maculaire peut évoluer et aggraver les troubles fonctionnels de la vision.
Symptômes du trou maculaire
Une personne présentant un trou maculaire peut avoir à faire, de manière brutale ou progressive, aux symptômes suivants :
- Une baisse de vision.
- Une amputation du champ visuel central (scotome).
- Une déformation dans la perception des images (métamorphopsies).
Quelle est la cause du trou maculaire?
Dans une très grande majorité des cas, l’apparition d’un trou maculaire est dû à un conflit entre la paroi du vitré (gel qui remplit la partie postérieure de l’œil) et la zone centrale de la rétine (macula). Peu à peu le vitré va se décoller et emporter avec lui la partie centrale de la macula, créant ainsi un trou maculaire. On parle de maladie de l’interface vitréo-rétinienne.
Néanmoins il existe également d’autres facteurs de risque tel que :
- La myopie forte.
- A la suite d’une chirurgie de la rétine ou d’un décollement de la rétine.
- Un traumatisme oculaire.
- A la suite d’une chirurgie de la cataracte.
- Si le patient a déjà eu un trou maculaire.

Diagnostic du trou maculaire
Pour faire le diagnostic du trou maculaire, l’ophtalmologiste procède à plusieurs examens :
- Un examen du fond d’œil à la lampe à fente pour examiner l’aspect du trou maculaire.
- Un examen du fond de l’œil par rétinographie afin d’examiner l’aspect du trou maculaire plus précisément.
- Un OCT maculaire permettant ensuite de mesurer la taille du trou maculaire ainsi que de le dater.

Traitement du trou maculaire
Les plus petits trous maculaires peuvent parfois se fermer d’eux-mêmes dans certains cas, il est néanmoins nécessaire de passer par l’intervention chirurgicale dans une majorité des cas.
L’intervention chirurgicale consiste à permettre la fermeture du trou maculaire afin de restaurer la vue du patient atteint. Le vitré est donc aspiré, on parle de vitrectomie et la rétine est assouplie par une dissection de la membrane qui entoure le trou maculaire. Le but de cette opération n’est pas de refermer directement le trou mais d’augmenter ses chances de fermeture de lui-même. Il s’agit de donner au tissu rétinien les meilleures conditions pour cicatriser.
Après le traitement du trou maculaire
Après l’opération, l’œil est rempli de gaz qui sera éliminé progressivement au fil des premières semaines qui suivent l’opération. Ce gaz trouble la vue du patient pendant environ un mois, jusqu’à son évacuation complète.
En fonction de la taille du trou maculaire, il peut être recommandé de maintenir la tête dans une certaine position une semaine après l’opération. Un rendez-vous de suivi sera à prévoir avec l’ophtalmologiste afin d’examiner la progression du traitement.

Résultats fonctionnels
Le taux de succès de l’opération du trou maculaire est haut, on compte 95% de fermeture après 1 chirurgie. Les chances de rétablissement sont également proportionnelles à la taille du trou maculaire : plus il sera grand, moins il sera aisé pour lui de se fermer.

Complications possible après un traitement du trou maculaire
Voici les complications possibles suite à un traitement du trou maculaire :
- Cataracte : la vitrectomie favorise en effet l’apparition d’une cataracte.
- Un échec de la fermeture du trou maculaire.
- Un récidive du trou maculaire.
- Apparition d’un œdème rétinien.
- Endophtalmie (infection de l’intérieur de l’œil).
